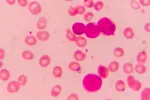
Leucemia al microscopio

Noticias sobre Salud Al Día
-

La FDA aprueba el uso del primer iris artificial
-

Crean nervios artificiales que podrían dotar de tacto a las prótesis
-

El insomnio, un efecto secundario adverso del ictus a largo plazo
-

El tabaco también puede ser letal para la salud cardiovascular
-

¿Puede la vacuna rVSV-ZEBOV frenar el nuevo brote de ébola?
-

Identifican un nuevo tipo de vértigo potencialmente tratable
-

Crean un gel que regenera neuronas cerebrales dañadas tras un ictus
-

Descubren cómo funciona el genoma de la leucemia linfática crónica
-

Primer fármaco para prevenir la migraña, aprobado por la FDA
-

Desarrollan un prometedor fármaco para frenar el resfriado
-

Casi la mitad de los pacientes con ETV sufre embolia de pulmón
-

Las mujeres con fibromialgia tienen alterado el control del equilibrio
-

Un nuevo test puede predecir la evolución de la esclerosis múltiple
-

El abuso del alcohol está relacionado con más de 200 enfermedades
-

Curan la diabetes en ratones usando islotes pancreáticos artificiales
-

Declaran un nuevo brote de Ébola en la República Democrática del Congo
Especial informativo
Lo más leído esta semana
- 1
La mala salud cardíaca en la mediana edad se asocia con más riesgo de demencia
- 2
Nace La RED, punto de encuentro anual para los expertos en Duchenne en España
- 3
Crean un parche que libera fármacos para reparar el corazón tras un infarto
- 4
Duchenne Parent Project reclama una ley que proteja a los pacientes con Duchenne
- 5
Los trastornos neurológicos causan la muerte de 11 millones de personas al año
- 6
Un gen de la longevidad podría combatir el envejecimiento prematuro en niños
- 7
La saliva, una aliada para predecir la evolución del cáncer de cabeza y cuello
- 8
Confirman la eficacia de la endoscopia para tratar lesiones rectales
- 9
La ELA se podría detectar precozmente con un simple análisis de sangre
- 10
La tasa de mortalidad mundial disminuye, pero mueren más personas jóvenes
Entrevista con el experto